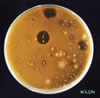

| Bakteriyosin |
|---|

Bakteriyosin |
| Bakteri zehir özü.Bazı bakteriler tarafından oluşturulan ve diğer bakteriler üzerinde olumsuz etki yapan antibiyotik benzeri maddelerdir. |
| Bakteriyosin |
|---|
Bakteriyosin |
| Bakteri zehir özü.Bazı bakteriler tarafından oluşturulan ve diğer bakteriler üzerinde olumsuz etki yapan antibiyotik benzeri maddelerdir. |